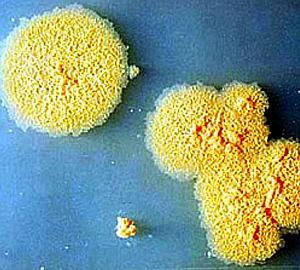
Esta bacteria nos hará más inteligentes

Esta bacteria nos hará más inteligentes
¿Puede la simple exposición a una bacteria influir de algún modo en nuestra capacidad cognitiva? ¿O llegar incluso a hacernos más inteligentes? Un estudio recién presentado en el Congreso de la Sociedad Americana de Microbiología, celebrado en San Diego, afirma que sí, que es ... posible. O por lo menos eso es lo que sugieren una serie de experimentos de laboratorio hechos con ratones.
Hasta ahora se sabía que la exposición a ciertas bacterias presentes en el ambiente puede tener ciertas cualidades antidepresivas, pero Dorothy Matthews y Susan Jenks, investigadoras de Sage Colleges, de Nueva York, han ido mucho más allá al sugerir que esas mismas bacterias también podrían incrementar nuestra capacidad de aprendizaje. " Mycobacterium vaccae -explica Dorothy Matthews- es un microorganismo de tierra que es ingerido o respirado de forma natural por las personas cuando pasan tiempo en el campo o en contacto con la naturaleza".
Investigaciones anteriores ya habían demostrado, además, que la inyección en ratones de M. vaccae (llamada así porque la primera cepa descrita fue aislada analizando el excremento de una vaca) estimulaba el crecimiento de determinadas neuronas en el cerebro, lo que provocaba a su vez un aumento en los niveles de serotonina y una disminución de la ansiedad. "Dado que la serotonina juega un papel importante en el aprendizaje, empezamos a preguntarnos si la propia M. vaccae también podía, por sí misma, estimular el aprendizaje en ratones", afirma Matthews.
Más rápidos y sin ansiedad
Así que se ambas se pusieron manos a la obra y añadieron bacterias vivas a la comida de algunos de sus ratones de laboratorio al mismo tiempo que estudiaban su capacidad para moverse dentro de un laberinto, comparándola con la de otros ratones que no habían ingerido la bacteria. "Encontramos que los ratones que habían ingerido M. vaccae recorrían el laberinto a más del doble de la velocidad , y con un nivel de ansiedad muy inferior al del resto de los ratones".
En un segundo experimento, se retiró la bacteria de la dieta de los roedores y se volvió a medir su capacidad para recorrer un laberinto. Todos ellos lo recorrieron más lentamente de lo que lo habían hecho mientras ingerían M. vaccae, aunque seguían siendo más rápidos que el resto. Tres semanas después de haber eliminado la bacteria de la dieta, las investigadoras realizaron un nuevo control. Los ratones experimentales seguían teniendo una cierta ventaja sobre los que jamás habían ingerido la bacteria, pero los resultados apenas si tenían una relevancia estadística, lo que sugiere que el efecto de las bacterias es temporal y depende de la continuidad del suministro.
"Nuestra investigación -concluye Matthews- sugiere que M. vaccae juega un papel en los niveles de ansiedad y los procesos de aprendizaje de los mamíferos. Y resulta interesante especular con la posibilidad de crear métodos de aprendizaje en las escuelas que incluyan pasar tiempo en ambientes en los que M. vaccae esté presente, lo que reducirá la ansiedad de los alumnos e incrementará su capacidad para aprender cosas nuevas".
Esta funcionalidad es sólo para suscriptores
Suscribete
Esta funcionalidad es sólo para registrados
Iniciar sesiónEsta funcionalidad es sólo para suscriptores
Suscribete